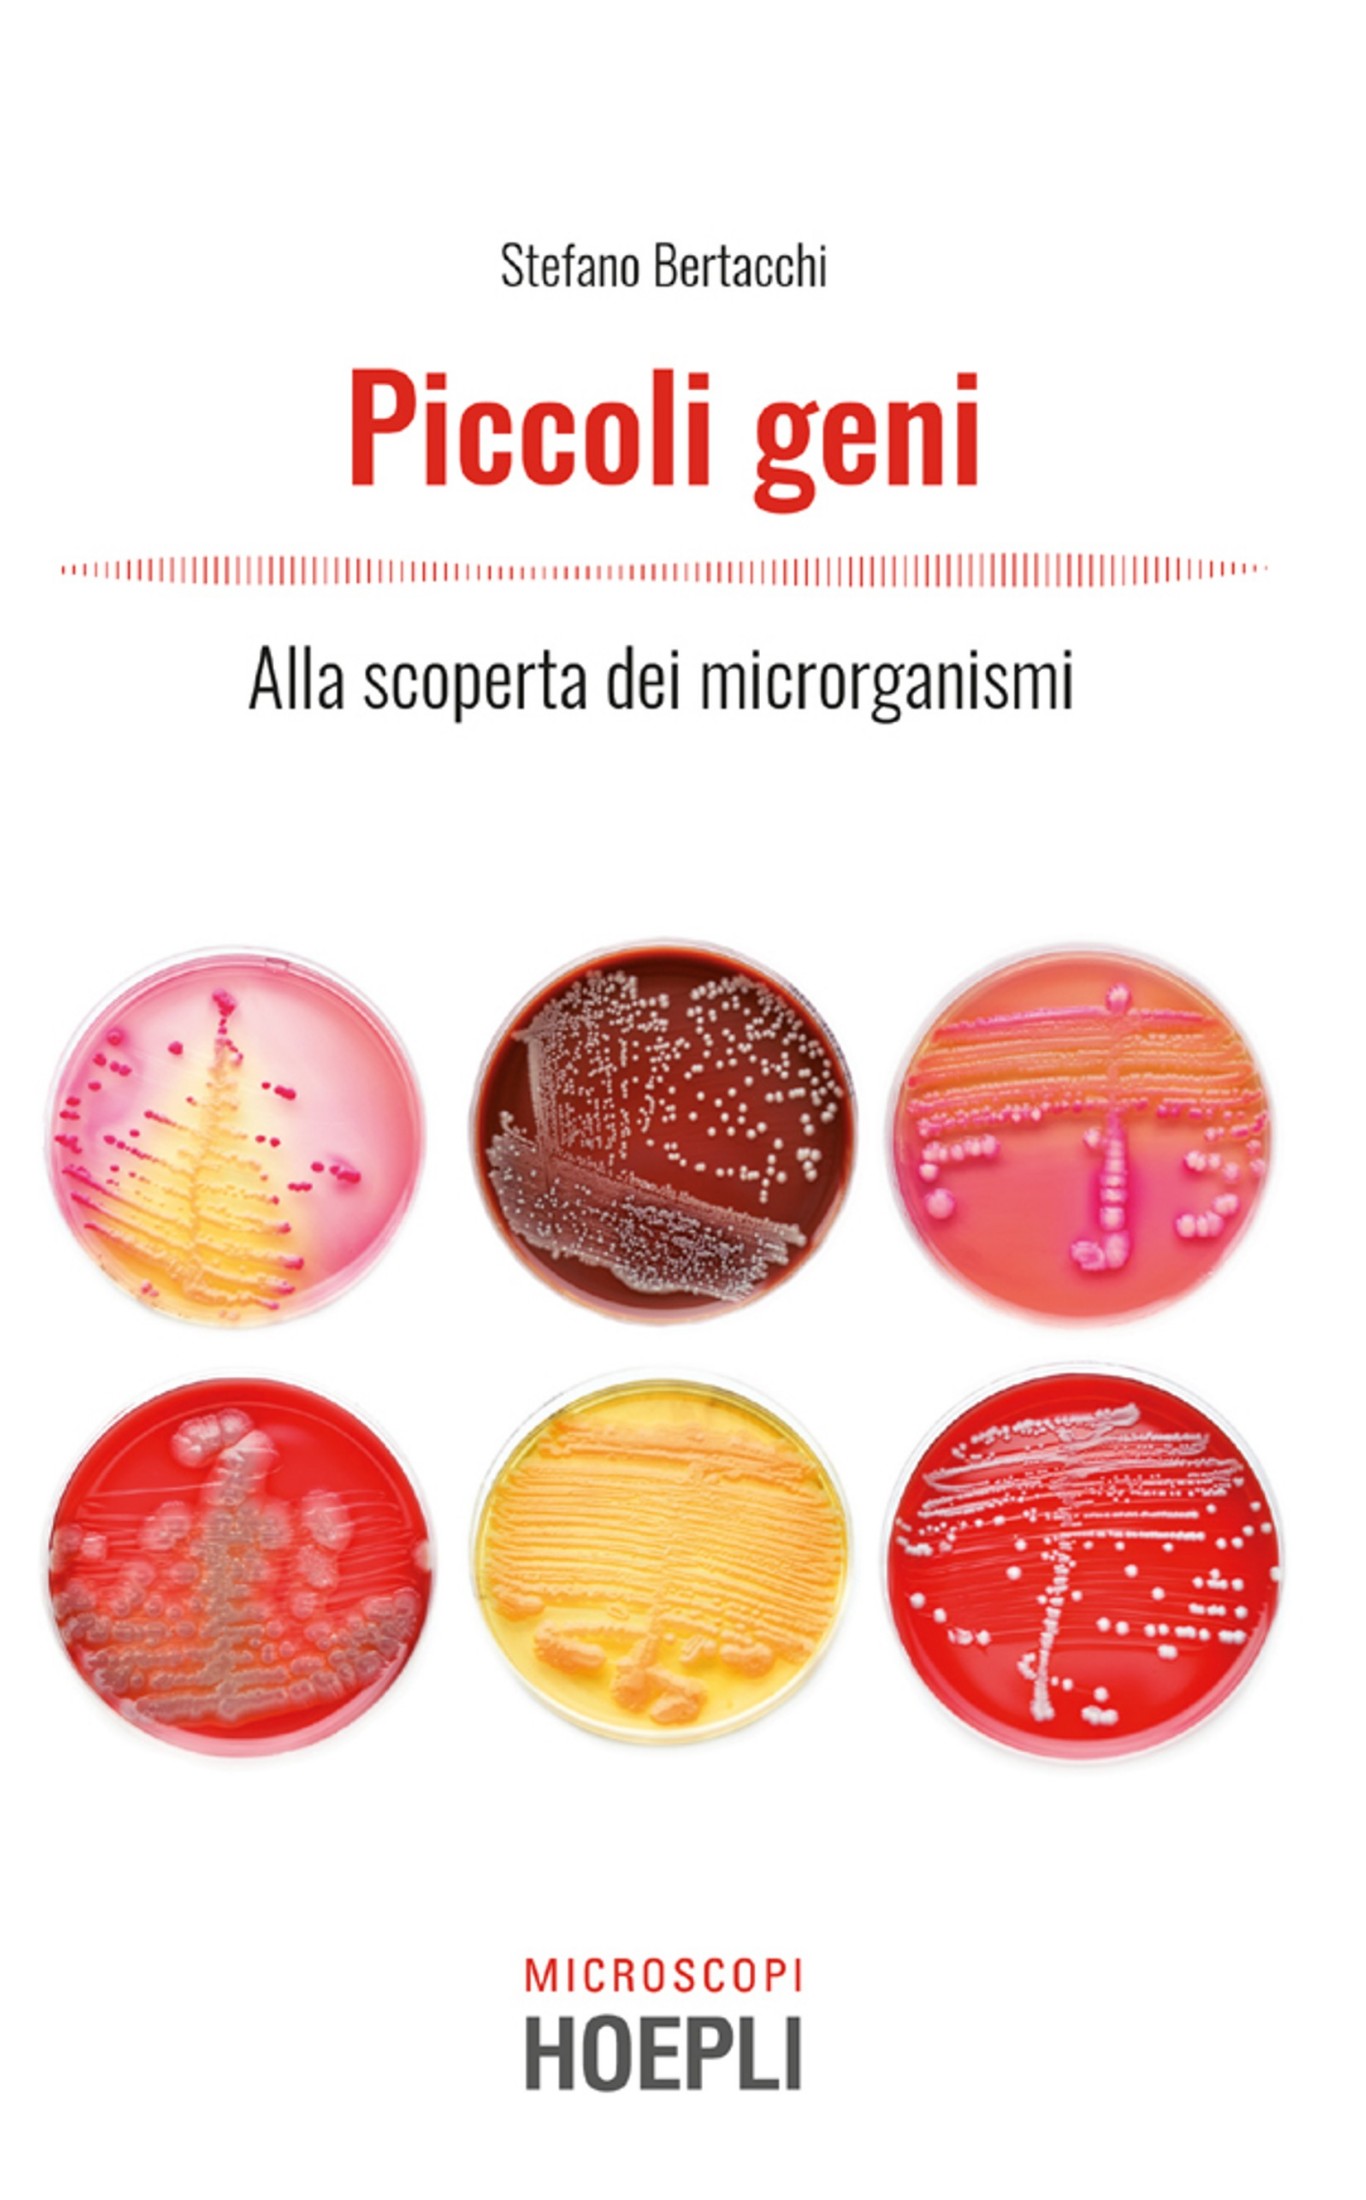

Alma

Il pretesto che dalla Francia porta Jérémie Felsen a Mauritius è un sasso, perfettamente rotondo, appartenuto al padre, ma sotteso al viaggio c'è un bisogno antico di entrare in quell'isola…[...]

Il pretesto che dalla Francia porta Jérémie Felsen a Mauritius è un sasso, perfettamente rotondo, appartenuto al padre, ma sotteso al viaggio c'è un bisogno antico di entrare in quell'isola…[...]

Belfast, 1972. Jean McConville, vedova e madre di dieci figli, ha trentotto anni quando, in un tardo pomeriggio di dicembre, una ventina di membri dell'ala estremista dell'IRA irrompe in casa…[...]

California, anni Zero. Bunny è bellissima, alta, bionda, con un padre costruttore edile e una piscina in giardino. Michael – coda di cavallo lungo la schiena e piercing al naso…[...]

È la notte di San Valentino quando in un parco della periferia capitolina viene scoperto il cadavere martoriato di un venditore di rose bengalese. Qualcuno ha infierito su di lui…[...]

*« Non mi ha regalato niente nessuno, questo e sicuro. E se sono orgoglioso di dove sono arrivato non e tanto per il ruolo che ricopro ma perche non dimentico…[...]

Fotografie. Nascoste dentro cassetti, infilate nelle pagine di vecchi libri, ammucchiate alla rinfusa in uno scatolone. La memoria e una scatola. Aprirla, guardare, ricordare, raccontare: e il disordine delle immagini…[...]

Piero Pelu il rocker, l'attivista, l'anarcoide, il brado, Piero Pelu il cantante, "el diablo", il pugile, il gigante: ebbene, dimenticatevi tutto questo e preparatevi a partire. Si, perche in questo…[...]
Un fantastico viaggio nel microcosmo, esplorando la straordinaria biodiversita microbica di batteri, lieviti e muffe, i cui nomi scientifici, a volte bizzarri e impronunciabili, nascondono incredibili caratteristiche. Dal fondo dell'oceano…[...]

In un vicoletto pressoché invisibile nel centro di Bologna, Vilo Vulcano mantiene in vita l’attività di famiglia: una libreria dalla scarsa clientela, ma ben conosciuta da chi ha problemi da…[...]

È una sera di ottobre a Los Angeles, e **Mickey Haller** , a bordo della sua Lincoln, si allontana dal bar dove ha offerto da bere a un nutrito gruppo…[...]